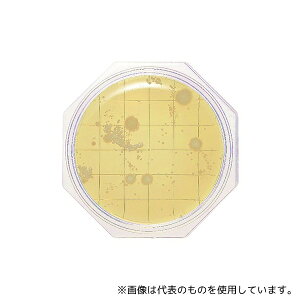
Ã_CAOmXeBNX 6791 N[X^v25ujbXCv SCDV(ʐېp) 30

「SCD」の人気商品一覧 | 安い商品を通販サイトから探す
1,949件 81〜120件を表示- 価格の安い順
- 価格の高い順
- 検索条件:
- 計測用具
- 本ページでは掲載するECサイトやメーカー等から購入実績などに基づいて手数料を受領しています。
![■AS スタンダード小型デシケーターSCD-1L〔品番:2791001〕【1010478:0】[送料別途見積り][掲外取寄][店頭受取不可]](https://tshop.r10s.jp/hcvalor-eshop/cabinet/trusco/1010/trusco-1010478.jpg?fitin=300:300)
その他の計測用具
7910-01《特長》●ステンレス筐体が静電気の影響を抑えます。●最大2段まで段積みが可能です(SCD-2H同士の2段積みはできません)。●本体背面に静電気対策用アース端子付きです。《用途》●材質:本体
測量用品
本体仕様 ●水平・勾配・0〜45°測定可能 ●アクリル樹脂 感度/精度 感度1.00mm/m=0.0573° 精度±17.5mm/m=±1.0°以内 ●いろいろな角度・勾配を測れます。 ●見やすい角
その他の計測用具
特徴 延長製法でしなやか頑丈、長寿命 仕様 呼び寸:1尺 長手(妻手)×幅×厚さ:340(165)×15×1.3mm 表裏目盛:長手/外目盛 1尺、妻手/外目盛 5寸 裏目盛:長手/外目盛 1尺、妻手/外目盛 5
この商品で絞り込む

測量用品
・携帯に便利なカードサイズの水平器! カラークリア 本体サイズ(cm)幅8.6×奥行5.5×高さ54 全長86mm 特徴これ1つで、いろいろな角度、勾配が測定可能です 用途水平、勾配、0〜45°測定に 商品説明カードサイズなので携帯に...

その他の計測用具
特長 ●ステンレス筐体が静電気の影響を抑えます。 ●最大2段まで段積みが可能です(SCD-2H同士の2段積みはできません)。 ●本体背面に静電気対策用アース端子付きです。 用途 ●材質:本体・棚板/ステンレス(SUS304)...

その他の計測用具
工具 用品 tool えびす EBISU DIAMOND ダイヤモンド 水平器 水平 垂直 高精度 測定 角度測定水平器 カードレベル カードサイズ 携帯 緑特長・いろいろな角度・勾配を測れます。・便利な目盛付きです。・カードサイズな...
この商品で絞り込む

その他の計測用具
本体仕様 ●水平・勾配・0〜45°測定可能 ●アクリル樹脂 感度/精度 感度1.00mm/m=0.0573° 精度±17.5mm/m=±1.0°以内 ●いろいろな角度・勾配を測れます。 ●見やすい角度目盛り。 ●カードサイズなので携帯...

その他の計測用具
【アズワン AS ONE】汎用器具・消耗品 金属・樹脂実験必需2 実験室必需用品、器具その他 商品の仕様 ● 【※ご注意ください】商品は代表の画像を使用しています。 【※ご注意ください】0

その他の計測用具
メーカーエビス商品カテゴリ測定工具>水平器・レベル発送目安1日〜2日以内に発送予定(土日祝除)お支払方法銀行振込・クレジットカード送料送料無料特記事項その他[測定工具]
この商品で絞り込む

測量用品
【送料都度見積】●長さ(mm):86●高さ(mm):54●厚さ(mm):5.5●最小表示:1度●感度:1.00mm/m=0.0573°●検出角度範囲(°):0〜45●測定精度(mm/m):±17.5=±1.0°以内
この商品で絞り込む

その他の計測用具
エビス 0120-18-5133 【商品説明】【特長】・いろいろな角度・勾配を測れます。・便利な目盛付きです。・カードサイズなので携帯に便利です。●本体仕様●水平・勾配・0〜45°測定可能●アクリル樹脂サイズ:5.5×54×86(m...
この商品で絞り込む

その他の計測用具
Oasis-X SCD41 CO2センサー ? 環境大気質モニタリング用CO2ガス検出器、二酸化炭素、温度および湿度センサーモジュール12C。

その他の計測用具
【アズワン AS ONE】分析・特殊機器 培養機器・容器 培地等 ●ぺたんと押して微生物チェックします。 ●特定の汚染菌の有無を選択的に確認できます。 ●一般細菌検出用培地は最短8時間で判定が可能です(発色液を使用)。 商品の仕様 ●...
この商品で絞り込む

その他の計測用具
【アズワン AS ONE】分析・特殊機器 培養機器・容器 培地等 商品の仕様 ● 【※ご注意ください】商品は代表の画像を使用しています。 【※ご注意ください】0

その他の計測用具
商品情報説明カードサイズで携帯に便利な多用途用水平器です。用途多用途用水平器。機能いろんな角度・勾配を測れます。見やすい角度目盛りです。水平・勾配・0〜45度の測定が可能です。仕様●感度:1.00mm/m=0.0573度。●精度:±1...
この商品で絞り込む

温湿度計
【アズワン AS ONE】物理・物性測定器 温度・湿度管理機器 温度・湿度管理関連機器 商品の仕様 ●入出力点数:入力8点/出力4点 【※ご注意ください】商品は代表の画像を使用しています。

その他の計測用具
培地等 ●日本薬局方適合の生培地です。 商品の仕様 ●型番:1.46004.0120 ●培地名:SCD寒天培地 ●容量(mL):30 ●入数:1箱(120枚入) ●※保存温度:-01/2〜25℃、その他/15〜25℃...

その他の計測用具
エビス 0120-18-5133 【商品説明】【特長】・いろいろな角度・勾配を測れます。・便利な目盛付きです。・カードサイズなので携帯に便利です。●本体仕様●水平・勾配・0〜45°測定可能●アクリル樹脂サイズ:5.5×54×86(m...
この商品で絞り込む

その他の計測用具
●カードサイズで携帯に便利な多用途用水平器です。●多用途用水平器。●いろんな角度・勾配を測れます。●見やすい角度目盛りです。●水平・勾配・0〜45度の測定が可能です。●感度:1.00mm/m=0.0573度●精度:±17.5mm/m=...
この商品で絞り込む

その他の計測用具
【アズワン AS ONE】分析・特殊機器 培養機器・容器 培地等 ●使いやすく信頼性の高い培地及び洗浄液で正確な無菌試験が可能です 商品の仕様 ●容量、mL:100 ●アプリケーション:無菌試験 ●テストの種類:無菌試験 ●テスト数/...

直尺・曲尺
【商品説明】●1分単位の目盛が見やすい階段状目盛です。●尺相当目は、連続追数字です。●直角が狂いにくい角厚タイプです。●高所作業に最適なセーフティーロープ取付穴付です。●直角測定に適した両面尺目盛です。●表面と裏面の目盛の位置が同じく...
この商品で絞り込む

その他の計測用具
【アズワン AS ONE】分析・特殊機器 分離・分析ロシ 分析機器その他 ●日本薬局方準拠培地 ●一般細菌用 商品の仕様 ●内容量:300g ●重量:438g ●※保存方法:室温・防湿 ●※有効期限:製造より3年 ●JANコード:49...
この商品で絞り込む

その他の計測用具
【アズワン AS ONE】分析・特殊機器 検査用品 微生物検査機器 ●無菌試験専用の液体培地です。 ●キャップ形状はシリンジ挿入用にセプタムキャップになっています。 ●シリンジ挿入部の汚染防止キャップ付です。 ●検査時における内容物視

その他の計測用具
特長 ●カード型の薄型角度計です。 ●カードサイズで薄型なので携帯に便利です。 ●いろいろな勾配や角度の測定が出来ます。 ●見やすい角度目盛り付です。 用途 ●水平・垂直・45°・勾配の測定に。 仕様 ●長さ(mm):86 ●高さ(m...
この商品で絞り込む

その他の計測用具
【アズワン AS ONE】分析・特殊機器 培養機器・容器 培地等 商品の仕様 ● 【※ご注意ください】商品は代表の画像を使用しています。 【※ご注意ください】0
この商品で絞り込む

その他の計測用具
【アズワン AS ONE】分析・特殊機器 検査用品 微生物検査機器 ●無菌試験専用の液体培地です。 ●キャップ形状はシリンジ挿入用にセプタムキャップになっています。 ●輸送時における破損防止のため、保護材でボトル上下が固定されていま

直尺・曲尺
●感度:0.70mm/m=0.0401° ●精度:±17.5mm/m=±1.0°以内 ■仕様 水平・垂直・勾配・0〜45度 測定可能 ●サイズ:86.5X54.3X5.6ミリ
この商品で絞り込む

その他の計測用具
アズワン AS ONE 研究用総合機器2021・サンクアスト2021掲載商品 分析・特殊機器>検査用品>微生物検査用品 ●培地調製の手間が省け、すぐお使いいただけます。 ●細菌検査の初心者から熟練者の方まで幅広くお使いいただけます。 ...
この商品で絞り込む

その他の計測用具
【アズワン AS ONE】分析・特殊機器 分離・分析ロシ 分析機器その他 ●日本薬局方準拠培地 ●一般細菌用 商品の仕様 ●入数:100枚 ●重量:4000g ●※保存方法:2〜25℃(常温) ●有効期限:製造後6ヶ月 ●★1枚あたり...
この商品で絞り込む

その他の計測用具
【アズワン AS ONE】分析・特殊機器 検査用品 微生物検査機器 ●無菌試験専用の液体培地です。 ●キャップ形状はシリンジ挿入用にセプタムキャップになっています。 ●シリンジ挿入部の汚染防止キャップ付です。 ●検査時における内容物視

その他の計測用具
ベクトン・ディッキンソン BD BBL(TM) γ線照射3重包装SCD寒天培地90mm RT 1個(1本×120枚入)●ガンマ線照射3重包装された局方対応の無菌エリア環境用です。●有効期限は6か月。●生培地...

その他の計測用具
特長●カードサイズで携帯に便利な多用途用水平器です。●いろんな角度・勾配を測れます。●見やすい角度目盛りです。●水平・勾配・0〜45度の測定が可能です。用途●多用途用水平器。材質/仕上●アクリル樹脂。仕様●感度:1.00mm/m=0.05
この商品で絞り込む

その他の計測用具
カードサイズで携帯に便利な多用途用水平器です。 ●【用途】多用途用水平器。 ●【機能・特長】いろんな角度・勾配を測れます。見やすい角度目盛りです。水平・勾配・0〜45度の測定が可能です。 ●アクリル樹脂。 ●エビススラントカー
この商品で絞り込む

その他の計測用具
特徴 いろいろな角度・勾配を測れます。 見やすい角度目盛り。 カードサイズなので携帯に便利です。 仕様 カラー:ホワイト×グリーン サイズ(mm):5.5×54×86 重量:23g 体
この商品で絞り込む

その他の計測用具
エビスダイヤモンド ED-SCD/ED-SCDR/ED-SCDBLエビスダイヤモンド全商品取り扱い中!!お探しはページ左上の商品検索窓で品番を入力!!

その他の計測用具
Frurdiem 5X SCD40ガスセンサーモジュール、検出CO2二酸化炭素、温度と湿度、2イン1センサー

その他の計測用具
工具 用品 tool えびす EBISU DIAMOND ダイヤモンド 水平器 水平 垂直 高精度 測定 角度測定水平器 カードレベル カードサイズ 携帯 緑特長・いろいろな角度・勾配を測れます。・便利な目盛付きです。・カードサイズな...
この商品で絞り込む
その他の計測用具
【アズワン AS ONE】分析・特殊機器 分離・分析ロシ 分析機器その他 ●日本薬局方準拠培地 ●環境微生物検査用 ●一般生菌数測定用 商品の仕様 ●培地表面積:25方センチメートル ●入数:30枚 ●重量:1020g ●※保存方法:...
この商品で絞り込む
![アズワン AS ONE スタンダード小型デシケーターSCD-2H 2-7910-02 [1445-0015568]](https://tshop.r10s.jp/daishinshop/cabinet/item/1445-11/1445-0015568.jpg?fitin=300:300)
その他の計測用具
納期目安 (メーカーに在庫がある場合)13:30までにご注文の場合約3〜7日後出荷(土日祝日を除く)※表示の納期目安はあくまで目安ですのでお約束ではありません。具体的納期は都度お問い合わせください。お取り寄せ品です!ご注文後[商
その他の計測用具カテゴリで検索されているキーワード:
お探しの商品はみつかりましたか?
検索条件の変更
ご利用前にお読み下さい
- ※ ご購入の前には必ずショップで最新情報をご確認下さい
- ※ 「掲載情報のご利用にあたって」を必ずご確認ください
- ※ 掲載している価格やスペック・付属品・画像など全ての情報は、万全の保証をいたしかねます。あらかじめご了承ください。
- ※ 各ショップの価格や在庫状況は常に変動しています。購入を検討する場合は、最新の情報を必ずご確認下さい。
- ※ ご購入の前には必ずショップのWebサイトで価格・利用規定等をご確認下さい。
- ※ 掲載しているスペック情報は万全な保証をいたしかねます。実際に購入を検討する場合は、必ず各メーカーへご確認ください。
- ※ ご購入の前にネット通販の注意点をご一読ください。
- ※ 本ページでは掲載するECサイトやメーカー等から購入実績などに基づいて手数料を受領しています。
- SCD
- DIY・工具
- 計測用具の通販情報・価格比較
- 価格.com
© Kakaku.com, Inc. All Rights Reserved. 無断転載禁止
